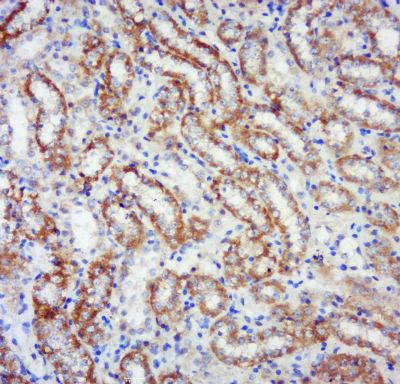
产品细节图片2

相关产品推荐更多 >
万千商家帮你免费找货
0 人在求购买到急需产品
- 详细信息
- 文献和实验
- 技术资料
- 供应商:
上海联迈生物工程有限公司
- 库存:
大量
- 目录编号:
LM-5673R
- 克隆性:
多克隆
- 抗原来源:
Rabbit
- 保质期:
1年
- 抗体英文名:
phospho-RPS6KB1(Ser441+Thr444)
- 抗体名:
磷酸化核糖体S6蛋白激酶抗体
- 宿主:
Rabbit
- 适应物种:
Human, Mouse, Rat, Chicken, Dog, Pig, Cow, Horse, Rabbit,
- 免疫原:
KLH conjugated Synthesised phosphopeptide derived from human RPS6KB1 around the phosphorylation site of Ser441+Thr444:IG(p-S)PR(p-T)PV
- 亚型:
IgG
- 形态:
Lyophilized or Liquid
- 应用范围:
WB=1:500-2000 ELISA=1:500-1000 IHC-P=1:400-800 IHC-F=1:400-800 IF=1:100-500 (石蜡切片需做抗原修复)
- 浓度:
1mg/ml
- 保存条件:
Store at -20 °C
- 规格:
100ul
| 英文名称 | phospho-RPS6KB1(Ser441+Thr444) |
| 中文名称 | 磷酸化核糖体S6蛋白激酶抗体 |
| 别 名 | RPS6KB1 (phospho S441+T444); RPS6KB1 (phospho Ser441+Thr444); p-RPS6KB1 (Ser441+Thr444); p70(S6K)-alpha; ribosomal protein S6 kinase; p70 S6 Kinase; P70 Beta1; KS6B1_HUMAN; Ribosomal protein S6 kinase beta-1; 70 kDa ribosomal protein S6 kinase 1; P70S6K1; p70-S6K 1; Ribosomal protein S6 kinase I; Serine/threonine-protein kinase 14A; p70 ribosomal S6 kinase alpha; p70 S6 kinase alpha; p70 S6K-alpha; p70 S6KA; S6K; PS6K; S6K1; STK14A; p70-S6K; p70 S6KA; p70-alpha; S6K-beta-1; p70(S6K)-alpha. |
| 规格价格 | 100ul/1580元 购买 大包装/询价 |
| 说 明 书 | 100ul |
| 产品类型 | 磷酸化抗体 |
| 研究领域 | 肿瘤 免疫学 信号转导 转录调节因子 |
| 抗体来源 | Rabbit |
| 克隆类型 | Polyclonal |
| 交叉反应 | Human, Mouse, Rat, Chicken, Dog, Pig, Cow, Horse, Rabbit, |
| 产品应用 | WB=1:500-2000 ELISA=1:500-1000 IHC-P=1:400-800 IHC-F=1:400-800 IF=1:100-500 (石蜡切片需做抗原修复) not yet tested in other applications. optimal dilutions/concentrations should be determined by the end user. |
| 分 子 量 | 58kDa |
| 细胞定位 | 细胞核 细胞浆 细胞膜 |
| 性 状 | Lyophilized or Liquid |
| 浓 度 | 1mg/ml |
| 免 疫 原 | KLH conjugated Synthesised phosphopeptide derived from human RPS6KB1 around the phosphorylation site of Ser441+Thr444:IG(p-S)PR(p-T)PV |
| 亚 型 | IgG |
| 纯化方法 | affinity purified by Protein A |
| 储 存 液 | 0.01M TBS(pH7.4) with 1% BSA, 0.03% Proclin300 and 50% Glycerol. |
| 保存条件 | Store at -20 °C for one year. Avoid repeated freeze/thaw cycles. The lyophilized antibody is stable at room temperature for at least one month and for greater than a year when kept at -20°C. When reconstituted in sterile pH 7.4 0.01M PBS or diluent of antibody the antibody is stable for at least two weeks at 2-4 °C. |
| PubMed | PubMed |
| 产品介绍 | background: This gene encodes a member of the ribosomal S6 kinase family of serine/threonine kinases. The encoded protein responds to mTOR (mammalian target of rapamycin) signaling to promote protein synthesis, cell growth, and cell proliferation. Activity of this gene has been associated with human cancer. Alternatively spliced transcript variants have been observed. The use of alternative translation start sites results in isoforms with longer or shorter N-termini which may differ in their subcellular localizations. There are two pseudogenes for this gene on chromosome 17. [provided by RefSeq, Jan 2013]. Function: Serine/threonine-protein kinase that acts downstream of mTOR signaling in response to growth factors and nutrients to promote cell proliferation, cell growth and cell cycle progression. Regulates protein synthesis through phosphorylation of EIF4B, RPS6 and EEF2K, and contributes to cell survival by repressing the pro-apoptotic function of BAD. Under conditions of nutrient depletion, the inactive form associates with the EIF3 translation initiation complex. Upon mitogenic stimulation, phosphorylation by the mammalian target of rapamycin complex 1 (mTORC1) leads to dissociation from the EIF3 complex and activation. The active form then phosphorylates and activates several substrates in the preinitiation complex, including the EIF2B complex and the cap-binding complex component EIF4B. Also controls translation initiation by phosphorylating a negative regulator of EIF4A, PDCD4, targeting it for ubiquitination and subsequent proteolysis. Promotes initiation of the pioneer round of protein synthesis by phosphorylating POLDIP3/SKAR. In response to IGF1, activates translation elongation by phosphorylating EEF2 kinase (EEF2K), which leads to its inhibition and thus activation of EEF2. Also plays a role in feedback regulation of mTORC2 by mTORC1 by phosphorylating RICTOR, resulting in the inhibition of mTORC2 and AKT1 signaling. Mediates cell survival by phosphorylating the pro-apoptotic protein BAD and suppressing its pro-apoptotic function. Phosphorylates mitochondrial URI1 leading to dissociation of a URI1-PPP1CC complex. The free mitochondrial PPP1CC can then dephosphorylate RPS6KB1 at 'Thr-412', which is proposed to be a negative feedback mechanism for the RPS6KB1 anti-apoptotic function. Mediates TNF-alpha-induced insulin resistance by phosphorylating IRS1 at multiple serine residues, resulting in accelerated degradation of IRS1. In cells lacking functional TSC1-2 complex, constitutively phosphorylates and inhibits GSK3B. May be involved in cytoskeletal rearrangement through binding to neurabin. Subunit: Interacts with PPP1R9A/neurabin-1. Interacts with RPTOR. Interacts with IRS1. Interacts with EIF3B and EIF3C. Interacts with POLDIP3 and TRAF4. Subcellular Location: Cell junction, synapse, synaptosome. Mitochondrion outer membrane. Mitochondrion.Note=Colocalizes with URI1 at mitochondrion. Isoform Alpha I: Nucleus. Cytoplasm. Isoform Alpha II: Cytoplasm. Tissue Specificity: Widely expressed. Post-translational modifications: Phosphorylation at Thr-412 is regulated by mTORC1. The phosphorylation at this site is maintained by an agonist-dependent autophosphorylation mechanism (By similarity). Activated by phosphorylation at Thr-252 by PDPK1. Dephosphorylation by PPP1CC at Thr-412 in mitochondrion. Similarity: Belongs to the protein kinase superfamily. AGC Ser/Thr protein kinase family. S6 kinase subfamily. Contains 1 AGC-kinase C-terminal domain. Contains 1 protein kinase domain. SWISS: P23443 Gene ID: 6198 Database links: Entrez Gene: 6198 Human Entrez Gene: 72508 Mouse Entrez Gene: 83840 Rat Omim: 608938 Human SwissProt: P23443 Human SwissProt: Q8BSK8 Mouse SwissProt: P67999 Rat Unigene: 463642 Human Unigene: 394280 Mouse Unigene: 446624 Mouse Unigene: 479484 Mouse Unigene: 4042 Rat Important Note: This product as supplied is intended for research use only, not for use in human, therapeutic or diagnostic applications. |
| 产品图片 | ![]() Sample: Heart (Mouse) Lysate at 40 ug Primary: Anti- phospho-RPS6KB1(Ser441+Thr444) (bs-5673R) at 1/300 dilution Secondary: IRDye800CW Goat Anti-Rabbit IgG at 1/20000 dilution Predicted band size: 58 kD Observed band size: 58 kD ![]() Tissue/cell: Rat kidney tissue; 4% Paraformaldehyde-fixed and paraffin-embedded; Antigen retrieval: citrate buffer ( 0.01M, pH 6.0 ), Boiling bathing for 15min; Block endogenous peroxidase by 3% Hydrogen peroxide for 30min; Blocking buffer (normal goat serum,C-0005) at 37∩ for 20 min; Incubation: Anti-phospho-RPS6KB1(Ser441+Thr444) Polyclonal Antibody, Unconjugated(bs-5673R) 1:400, overnight at 4∑C, followed by conjugation to the secondary antibody(SP-0023) and DAB(C-0010) staining ![]() Tissue/cell: Rat brain tissue; 4% Paraformaldehyde-fixed and paraffin-embedded; Antigen retrieval: citrate buffer ( 0.01M, pH 6.0 ), Boiling bathing for 15min; Block endogenous peroxidase by 3% Hydrogen peroxide for 30min; Blocking buffer (normal goat serum,C-0005) at 37∩ for 20 min; Incubation: Anti-phospho-RPS6KB1(Ser441+Thr444) Polyclonal Antibody, Unconjugated(bs-5673R) 1:400, overnight at 4∑C, followed by conjugation to the secondary antibody(SP-0023) and DAB(C-0010) staining |
风险提示:丁香通仅作为第三方平台,为商家信息发布提供平台空间。用户咨询产品时请注意保护个人信息及财产安全,合理判断,谨慎选购商品,商家和用户对交易行为负责。对于医疗器械类产品,请先查证核实企业经营资质和医疗器械产品注册证情况。
文献和实验Using Phospho‐Motif Antibodies to Determine Kinase Substrates
, which may be used to specifically detect Ser, Thr, Ser/Thr, or Tyr residues phosphorylated by different protein kinase families. These antibodies are commonly used in immunoprecipitation and/or immunoblotting protocols to determine kinase?induced substrate
【求助】P53的翻译后修饰都有哪些? 怎样验证其修饰后与靶标启动子的结合活性的变化?
蛋白质功能的一个主要机制,p53在多个位点上可被磷酸化、顺-反异构化、乙酰化、泛素化、甲基化、糖基化等修饰,从而显示其生物学重要性。这种显示细胞或组织特异性并依赖细胞周期位置的多重修饰,是一种复杂的调节方式,随着细胞对DNA损伤、增殖、老化等产生的细胞信号的反应而发生波动。 磷酸化修饰 P53的磷酸化在多数情况下与蛋白质的稳定性有关。p53 N-末端的三个位点Ser15、Thr18、Ser20磷酸化后,使p53和其主要的负性调节因子MDM2之间的相互作用消失,而和乙
提示我模型中的通路究竟涉及哪个亚型,而我又没有那么多经费一个一个亚型去试,故我想能不能就检测总的PKC激活水平,毕竟有亚型被激活,那总的活化PKC水平也应该会升高啊!虽然敏感性和特异性肯定没有单独检测一个亚型的高。 还想请教:Phospho-PKC (pan) (gamma Thr514) Antibody 和Phospho-PKC (pan) (βII Ser660) Antibody 这两个抗体的针对的亚型有什么不同?既然都是pan,那是否说都是针对所有的亚型,只是磷酸化的残基不同
技术资料暂无技术资料 索取技术资料